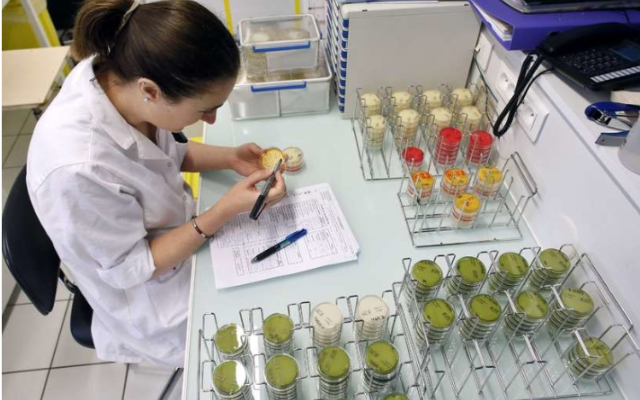

Thought Leader and Influencer Interview with Adriana Rivas, COO & AI Strategist, Bigwise Corp
At a Glance Adriana Rivas COO & AI Strategist, Bigwise Corp Focus Areas: Retail, Agentic…












Leveraging our patented credentialing algorithms and advanced technology platform, enterprises across all business functions can seamlessly source world-class talent, procure specialized services, and deploy cutting-edge AI solutions. Concurrently, individual professionals and brands use our network to validate their intellectual capital, benchmark their standing, and earn world-renowned industry certifications and awards.
5G, Agentic AI, AGI, Agile, AI, AI Ethics, AI Governance, AI Infrastructure, AI Orchestration, AI Safety, Analytics, Architecture, AR/VR, Automotive, Autonomous Vehicles, Behavioral Science, Big Data, Blockchain, Business Continuity, Business Strategy, Careers, Change Management, Climate Change, Cloud, Coaching, Construction, COVID-19, Corporate Social Responsibility, Creativity, CRM, Cryptocurrency, Culture, Customer Experience, Customer Loyalty, Cybersecurity, Data Center, Design, Design Thinking, DevOps, Digital Disruption, Digital Transformation, Digital Twins, Diversity & Inclusion, Drones, eCommerce, Economics, Ecosystems, EdTech, Education, Emerging Technology, Energy, Engineering, Entrepreneurship, ERP, Finance, FinTech, Generative AI, GovTech, GRC, Health & Safety, Health & Wellness, Healthcare, HealthTech, HR, Innovation, InsurTech, International Relations, IoT, IT Leadership, IT Operations, IT Strategy, Leadership, Lean Startup, Legal & IP, Management, Manufacturing, Marketing, Mental Health, Mergers & Acquisitions, Metaverse, Mobility, National Security, NFT, Open Innovation, Open Source, Payroll, Personal Branding, Predictive Analytics, Privacy, Procurement, Product Management, Project Management, PropTech, Public Relations, Quantum AI, Quantum Computing, Recruiting, RegTech, Renewable Energy, Retail, Risk Management, Robotics, RPA, Sales, Security, Smart Cities, Social, Sports, SportsTech, Startups, Supply Chain, Sustainability, Telecom, Transformation, Transportation, Travel and Venture Capital.






















Post a project opportunity for free, or claim your expert credentials today.


At a Glance Adriana Rivas COO & AI Strategist, Bigwise Corp Focus Areas: Retail, Agentic…
At a Glance Germain St-Denis, Architect of People First™, Author & Keynote Speaker Focus Areas:…
At a Glance Udit K Kerney, Principal Consultant, Straven & Co Focus Areas: AI, AI…
At a Glance George S. Mentz, Founder & CEO, Global Academy of Finance & Management…
At a Glance Raluca Cibu-Buzac, Founder and CEO of Luminspino and SunChild Focus Areas: Change…
At a Glance Aravind Sakthivel, IT leader, Author, Technologist Focus Areas: IT Leadership, Artificial Intelligence,…
At a Glance Sara Roberts, HealthTech Entrepreneur and Founder, Well Purposed Focus Areas: Entrepreneurship, HealthTech,…
At a Glance Roger Spitz, President, Techistential & Chair, Disruptive Futures Institute Focus Areas: AI,…




Seeking to expand its brand awareness, SAP Ariba needed a…
Seeking to raise its brand awareness, PROS needed a capable…
Seeking to grow its market share, PlexiCam needed a capable…
Seeking to raise its brand awareness, the IBM Center for…
CISCO creates and amplifies its thought leadership content via the…



















Thinkers360 | Post

kaynemcgladrey.com | Article/Blog

medium.com | Article/Blog

medium.com | Article/Blog

www.linkedin.com | Article/Blog

www.linkedin.com | Article/Blog
www.linkedin.com | Article/Blog

Here’s the Thinkers360TM annual leaderboard for our top 50 global thought leaders, analysts and influencers on Culture. Congratulations to all our…
Here’s the Thinkers360TM annual leaderboard for our top 50 global thought leaders, analysts and influencers on Business Continuity. Congratulations to all…

Join the Thinkers360 community today! Join the world’s premier thought leaders, showcase your profile, amplify your content, earn badges and credentials, and connect with global brands in our B2B expert & AI marketplace.
As a creator in Data and AI, I don’t just need reach, I need credibility with decision makers. Thinkers360 helps me do that. It puts my work in front of enterprise buyers and executives, not just random traffic, and it does it in a way that’s based on actual contributions, not vanity metrics. The badges, rankings, and topical leaderboards give social proof I can show to sponsors, conference teams, and press. And because the platform is built around B2B thought leaders with a combined audience in the hundreds of millions, it has opened doors to interviews, paid collaborations, and speaking requests that I wouldn’t have seen on the usual social channels. It’s become part of how I present my brand. Great work Nick and Team.

As a Cisco senior writer and content creator, the Thinkers360 community has been a key resource. With access to leaders, SMEs, and visionaries from all areas of technology and industry, I can pull in the critical external insights that give our thought leadership the wide perspective it demands. In addition, the team have helped amplify our content to a highly diverse, and powerfully influential audience of decision makers around the world.

As an analyst, author and podcast host, I value how Thinkers360 bridges experts across industries and amplifies thoughtful content. The platform’s commitment to authentic thought leadership, not just buzz, has delivered meaningful recognition and continues to expand my professional brand.

Thinkers360 is a great platform for getting the word out about my writing and expertise as well as expanding my network of thought leaders. I particularly value the rankings and regular digest emails, as they bring me into contact with professionals, content, and ideas I might otherwise have missed.

Thinkers360 delivers a continuous system of record for thought leadership allowing us to communicate each of our expertise and ideas to like-minded and positive professionals. It is a uniquely useful platform for connecting and expanding personal and global brands and for stimulating communication to promote ideas. I couldn’t have made so many valuable connections bridging each of the commercial and academic worlds as quickly as I have in any other way.

I joined Thinkers360 to connect with other Thought Leaders in the industry, build my network, and learn from them. I was pleasantly surprised to see traffic coming to my website through Thinkers360. It was nice to be recognized as a Thought Leader based on my work.

In a world where information and opinions are a commodity, Thinkers360 connects insights that go beyond B2B, they bring real people, real experiences, and real insights together in a valuable P2P (people-to-people) network.

Joining Thinkers360 has been one of my best business decisions made. The value of investing in the Pro Plan enabled me to align and share insights with other global thought leaders at a record pace. It’s thrilling to engage, learn and grow in so many diverse verticals, and this further highlights the power of Thinkers360 and value of human connection!

Trying to weed out thought leaders who actually have the ability and the knowledge to share and influence trends is always challenging. Thinkers360 finally has put in place the foundation for doing this in an objective, credibly, and thorough manner. For me, it’s the modern day Who’s Who of thought leadership.

It’s hard to create ideas that can transform business and even harder to get those ideas heard. As a new nonfiction business author, Thinkers360 has been an invaluable partner, helping to cement my influence and impact and providing opportunities for collaboration with an equally ambitious and capable peer group of other executive advisors. A great investment!

Thinkers360 is a great platform to connect, share content and get great insights. It’s amazing seeing the large number of influencers on the platform sharing ideas, content and exchanging best practices. Worth joining!

